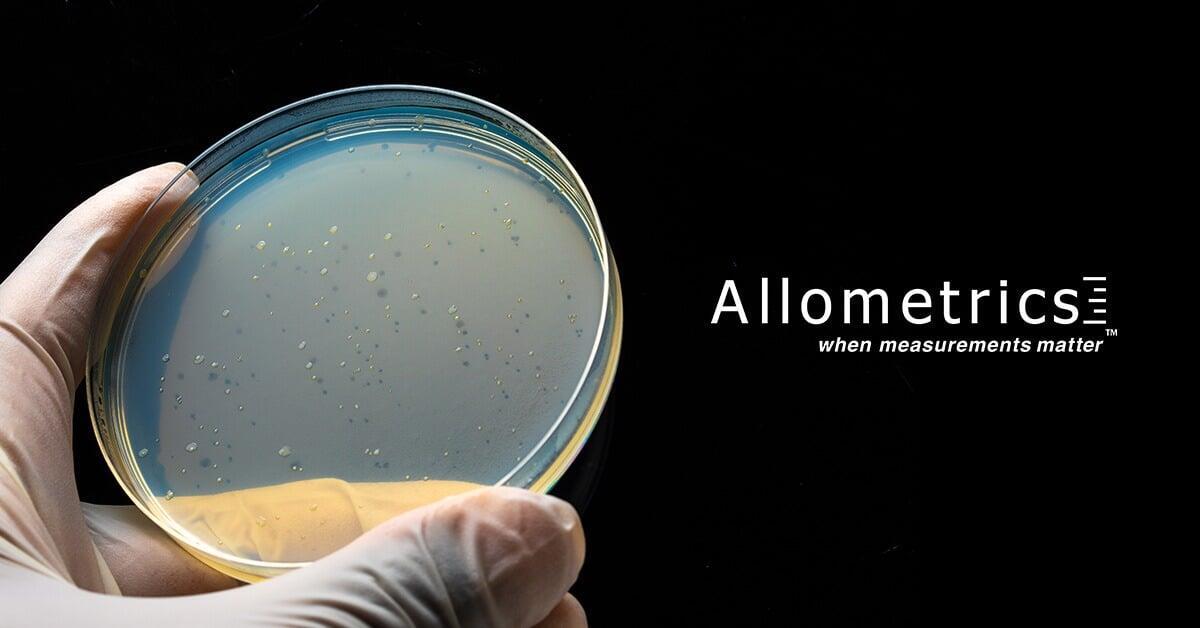
MONTHLY SURFACE SAMPLING WHY IT’S NEEDED

Resources
Knowing how to interpret a calibration certificate can help prevent costly mistakes. While most companies realize they require periodic certification of their measuring instruments, not everyone knows how to review them correctly. Today we’ll help you learn how to verify calibration certificat...
The benefit of on-site calibration is that you do not have to send out all your equipment off-site for calibration. By calibrating and adjusting your equipment regularly, you will be able to measure safely, ensure compliance, and avoid the costs of inaccurate measurements. There is no doubt that cal...
Way back in the 1996, we were approached by two regional crime labs to calibrate their pipettes. We were, at that time, a gravimetrics calibration company and had never calibrated volumetric apparatus. I asked them to give me a couple of weeks to research the subject. I discovered that all volumetri...
In the field of aircraft maintenance, accuracy is paramount to safety. Calibration and testing are essential for any piece of precision equipment or tool used to certify the airworthiness of an airplane or any of its components.
Given the importance of accurate readings during an inspection, aircraft...
In the world of pharmaceuticals, environmental safety is imperative. Medicines need to be pure and free of any foreign contaminants.
Purity standards for oral medications have high limits set for bacteria and fungi. Injectables such as vaccines have no tolerance for even the minimum amounts of contam...
Learn about the traits of an excellent calibration company to separate the good from the excellent. If you are the head of the operations and maintenance department, chances are you don’t feel any excitement when the topic of equipment calibration comes up.
Let’s face it; precision equipment calibrat...
Working with out-of-tolerance equipment may have severe implications in different segments of your business, including product quality, plant or lab productivity, safety, and profits.
How Important Are Scheduled Calibrations?
When your instruments or the sensors built into them suffer temperature vari...
The meatpacking industry is a vital economic force, employing nearly 200,000 people in direct meat processing jobs in 2019.
Yet the very nature of the work makes meatpacking plants a dangerous work environment. Not only does the job require the use of knives, saws, and operating industrial meat grind...
The big question today, “How do I minimize the COVID-19 risk and get back to work?” As the country grapples with the novel coronavirus that causes COVID-19 infections, businesses across the country are searching for cost-effective ways to keep their staff and clients safe.
Food processing plant...
Any industry that requires a sterile environment to maintain its operational integrity and compliance knows just how vital cleanroom certification services are.
Settings such as compounding pharmacies, hospital laboratories, and research facilities must comply with strict USP regulations and must mai...
Temperature mapping is essential, whether it’s fridges and freezers or your whole warehouse that needs to be climate controlled. Understanding the ins and out of it can save you lots of money.
What is Temperature Mapping?
Also known as thermal mapping, temperature mapping is considered a Good Manufact...
Environmental science is a growing interdisciplinary field that integrates physical, biological, and information sciences.
Environmental science focuses not only in studying Earth’s environment but also in finding solutions to the world’s most pressing environmental problems. As such, it’s appl...
Frozen foods are not a modern invention. This method of food preservation was common practice in cold regions for centuries.
Freezing inhibits the growth of microorganisms that decompose and spoil food. The key to keeping the product’s integrity is to freeze it instantly and keep it that way until it...
The Importance of Temperature Mapping
Temperature mapping is essential for maintaining consistent temperatures in environments like warehouses, environmental chambers, and coolers. It involves identifying hot or cold spots, complying with industry standards, and meticulously measuring and record...
The answer is, yes. Tools really need calibration! Get advise from the experts at Allometrics Inc, a top-rated ISO 17025 accredited calibration company since 1976. Tools are necessary to perform a range of processes in many industries, from manufacturing to environmental ...
To get precise and trustworthy results, it’s crucial to maintain lab equipment properly. Clean surfaces regularly with suitable solutions, follow manufacturer guidelines for maintenance and calibration, and promptly address any wear or damage. Lab personnel should undergo regular training on equipme...
Hospitals and COVID-19 testing laboratories are working overtime to diagnose and treat patients. The overwhelming amount of new and active cases at some of these facilities puts added pressure on healthcare workers to try and maintain their work environment safe.
The World Health Organization updates...
The recent rollout of COVID-19 vaccines has put enormous pressure on vaccine coordinators, distributors, and administering healthcare facilities.
The storage temperature requirements for both the Pfizer and Modena vaccines far exceed the regular refrigerators’ capabilities and have inadv...
Allometrics is an ISO 17025 accredited calibration company that sells, certifies, services, and repairs process instrumentation, weighing devices, controlled environments, measuring and test equipment for laboratories in a wide range of industries. Allometrics is seeking a Customer Service Represent...
Categories
- Uncategorized
(90)
- Fume Hoods
(1)
- Calibration
(2)
- BioSafety Cabinets
(1)